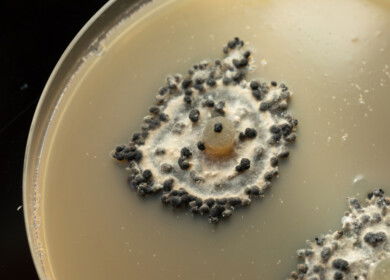
Soil fungus shows potential to replace chemical fungicides

Brazilian scientists discover Antarctic fungus with biopesticide potential

A collaborative effort between Brazilian and American researchers has led to the discovery of a new fungus species, Penicillium palitans, in the deep marine sediments of the Southern Ocean in Antarctica. This fungus produces bioactive substances that may be pivotal in developing natural biopesticides.
The institutions involved in this groundbreaking research include the Federal University of Minas Gerais (UFMG), Brazilian Agricultural Research Corporation (Embrapa), and the United States Department of Agriculture (USDA). The team identified substances with antifungal and phytotoxic properties that hold promise as sustainable alternatives to traditional synthetic agrochemicals.
Penienone and palitantin are the two main substances isolated from Penicillium palitans. Penienone, in particular, demonstrated potent antifungal and phytotoxic activity, effectively halting the germination of bentgrass seeds even at minimal concentrations and combating Colletotrichum fragariae, a pathogen responsible for anthracnose in various crops. Palitantin exhibited moderate phytotoxic effects.

According to Débora Barreto from UFMG, Antarctica’s extreme environmental conditions foster a unique microbial biodiversity, making it an ideal location for biotechnological research. The extremophiles from this region, adapted to freezing temperatures and high salinity, are potential sources of novel biotechnological applications.
Luiz Rosa, a professor at the Department of Microbiology at UFMG and the study’s coordinator, noted the significance of these findings in addressing the challenges posed by synthetic pesticides, including pest resistance and environmental degradation.
Sonia Queiroz from Embrapa highlighted the potential of these discoveries to align with the One Health concept by reducing reliance on synthetic chemicals. However, the transition from laboratory findings to commercial products will require extensive testing to confirm their safety, stability, and effectiveness in agricultural settings.
“The next steps involve expanding toxicological and ecotoxicological studies and examining the feasibility of mass production,” Rosa stated, suggesting possible collaborations with agricultural businesses.
This research is part of Brazil’s Antarctic Program (Proantar) and receives support from the National Council for Scientific and Technological Development (CNPq) and logistical assistance from the Brazilian Navy through the Secretariat of the Interministerial Commission for Sea Resources (Secirm).
Enjoyed this story?
Every Monday, our subscribers get their hands on a digest of the most trending agriculture news. You can join them too!

Discussion0 comments